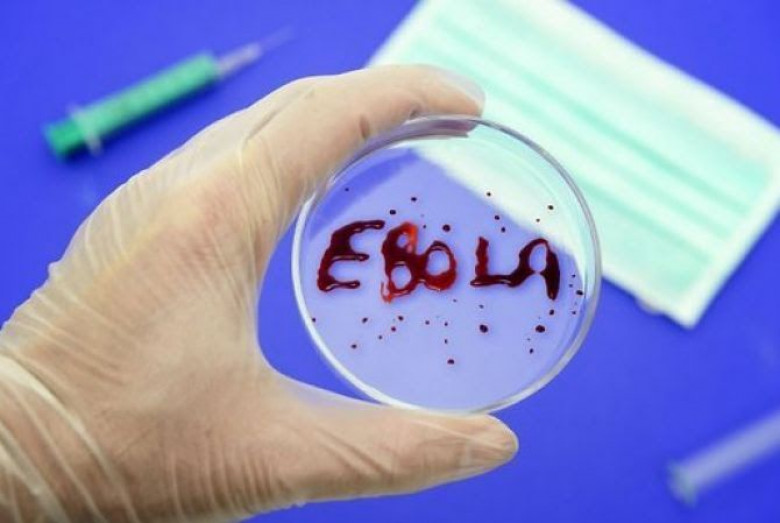

Գվինեան հայտարարել է երկրում Էբոլայով վարակված վերջին հիվանդի բուժվելու մասին
Միջազգային
Գվինեայի Հանրապետության կառավարությունը հայտարարել է, որ բուժվել է Էբոլա վիրուսի՝ վերջին գրանցված կրողը: Նոյեմբերի 17-ին 19-օրական մանկիկը, որը վիրուսի վերջին կրողն էր երկրում, դուրս է գրվել Գվինեայի մայրաքաղաք Կոնակրիի հիվանդանոցից:
Երեխան վիրուսով վարակվել էր արգանդում՝ իր մորից: Կնոջը բուժել չի հաջողվել:
Գվինեան դարձել է արեւմտաֆրիկյան երկրներից վերջինը, որը հայտարարել է, թե Էբոլա վիրուսն իր տարածքում վերացված է: Հենց Գվինեայում էր երկու տարի առաջ սկսվել վիրուսի համաճարակը, որը 11 հազար մարդու կյանք խլեց: Գվինեան եւ հարեւան Սիեռա Լեոնեն ու Լիբերիան աֆրիկյան մնացած բոլոր երկրներից առավել շատ են տուժել վիրուսից:
Լիբերիան Էբոլայից ազատ է հայտարարվել սեպտեմբերի վերջին, Սիեռա Լեոնեն՝ նոյեմբերի սկզբին: